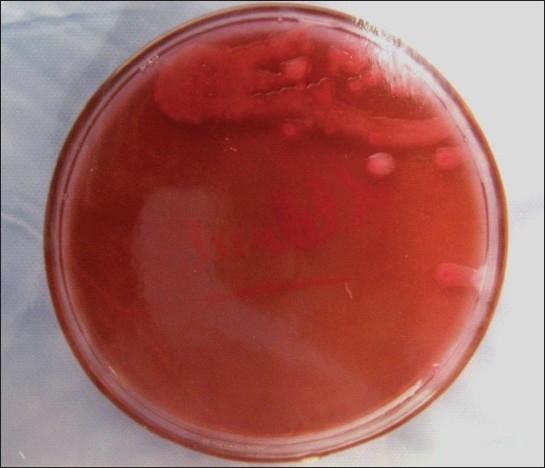
https://cdn.ncbi.nlm.nih.gov/pmc/blobs/63ba/2933524/01963a05ac96/JISP-14-18-g003.jpg
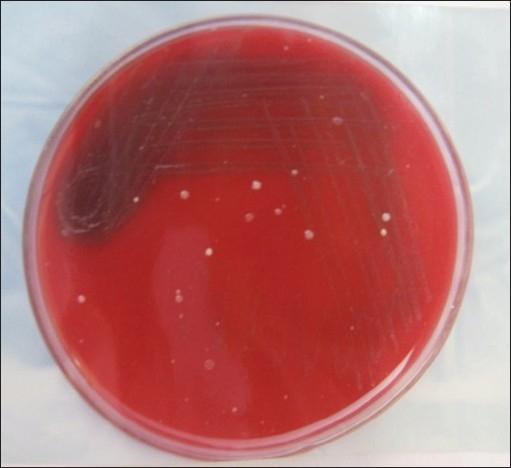
https://cdn.ncbi.nlm.nih.gov/pmc/blobs/63ba/2933524/9a5aecf7be46/JISP-14-18-g004.jpg

牙周瓣手术中术后菌血症:预防性使用抗生素与未使用抗生素的比较研究
Postoperative bacteremia in periodontal flap surgery, with and without prophylactic antibiotic administration: A comparative study.
作者信息
Asi Kanwarjit S, Gill Amarjit S, Mahajan Sunil
机构信息
Department of Periodontics, Krishna Dental College, 95 Loni Road, Mohan Nagar, Ghaziabad, UP, India.
出版信息
J Indian Soc Periodontol. 2010 Jan;14(1):18-22. doi: 10.4103/0972-124X.65430.
OBJECTIVES
Many a times in clinical periodontology, the decision whether to prescribe prophylactic antibiotics or not, is perplexing.The present study was conducted to compare the bacteremias induced after periodontal flap surgeries with and without prophylactic antibiotics.
MATERIALS AND METHODS
The occurrence of postoperative bacteremia following periodontal flap surgery was studied in 30 patients. On these patients, 30 quadrant wise flap surgeries were carried out without any preoperative prophylactic antibiotics and 30 surgeries carried out after prophylactic administration of amoxycillin preoperatively. A blood sample was taken from each patient at the time of maximum surgical trauma and was cultured for micro-organisms and antibiotic sensitivity.
RESULTS
18 out of 60 blood samples were positive for micro-organisms. There was a significant reduction in post operative bacteremia after amoxycillin prophylaxis (x(2) - 7.96 with P<0.01) as post operative bacteremia was found in 14 of the non medicated patients as compared to only 4 of the pre medicated patients. The micro-organisms encountered in the study are as follows:- 1) Staphylococcus albus coagulase negative, 2) Klebsiella, 3) Psedomonas aerugenosa, 4) Streptococcus viridans, 5) Alpha hemolytic streptococcus, 6) Neisseria catarrhalis
CONCLUSION
On the basis of the study, it is concluded that the incidence of postoperative bacteremia following periodontal flap surgery is not as high as previously reported. The clinical results show that Amoxicillin is highly effective in reducing postoperative bacteremia in periodontal flap surgery and thus in preventing the possible sequelae (Infective Endocarditis and other systemic maladies) in susceptible patients. However, cefotaxime and cephalexin may prove to be more effective in preventing the same.
目的
在临床牙周病学中,很多时候决定是否开具预防性抗生素是令人困惑的。本研究旨在比较牙周翻瓣手术在使用和不使用预防性抗生素情况下引发的菌血症。
材料与方法
对30例患者进行了牙周翻瓣手术后术后菌血症发生情况的研究。对这些患者,在未进行任何术前预防性抗生素治疗的情况下进行了30个象限的翻瓣手术,以及在术前预防性给予阿莫西林后进行了30例手术。在手术创伤最大时从每位患者采集血样,培养微生物并检测抗生素敏感性。
结果
60份血样中有18份微生物检测呈阳性。阿莫西林预防后术后菌血症显著降低(χ² = 7.96,P < 0.01),因为未用药患者中有14例发生术后菌血症,而用药患者中只有4例。研究中发现的微生物如下:1)凝固酶阴性白色葡萄球菌,2)克雷伯菌属,3)铜绿假单胞菌,4)草绿色链球菌,5)甲型溶血性链球菌,6)卡他莫拉菌
结论
基于该研究,得出结论:牙周翻瓣手术后术后菌血症的发生率并不像先前报道的那么高。临床结果表明,阿莫西林在降低牙周翻瓣手术术后菌血症方面非常有效,从而在预防易感患者可能出现的后遗症(感染性心内膜炎和其他全身性疾病)方面有效。然而,头孢噻肟和头孢氨苄可能在预防方面更有效。